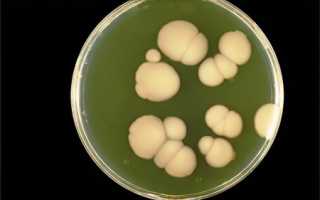

Симптомы грибка в ушах
Симптоматика грибка в ушах варьируется в зависимости от пораженной области. Обычно симптомы усиливаются по мере распространения мицелия в более глубокие слои кожи, что приводит к механическим повреждениям и токсическому воздействию.
-
Симптомы грибка наружного уха. Заболевание часто начинается с потери защитной жировой пленки, покрывающей кожу слухового прохода. Это может произойти из-за мелких травм или повышенной влажности. В результате слуховой проход отекает, а железы в его коже закупориваются. На этом этапе пациент ощущает зуд и заложенность в ухе. Многие ошибочно полагают, что дискомфорт вызван серной пробкой или загрязнением, и пытаются самостоятельно очистить ухо, что может повредить кожу и способствовать проникновению грибковой инфекции. В итоге развивается острый отомикоз, при котором усиливаются отечность и покраснение кожи наружного уха.
Острая стадия заболевания сопровождается увеличением объема выделений. Цвет выделений зависит от типа грибка. Если возбудителем являются плесневые грибы, экссудат может напоминать казеозные массы, похожие на влажную бумагу, с оттенками от черно-коричневого до желтовато-зеленого. При пенициллезе выделения имеют цвет, схожий с ушной серой.
При сильном отеке просвет слухового прохода может полностью перекрываться, что приводит к шуму в ухе и выраженной тугоухости, так как звук с трудом достигает барабанной перепонки.
Интенсивные болевые ощущения всегда сопровождают острую стадию грибка наружного уха. Боль может усиливаться при глотании и во время бритья. Вместе с выделениями могут выходить слепки, содержащие мицелий грибков и клетки эпидермиса.
Часто наблюдается региональный лимфаденит — воспаление лимфатических узлов, которое может затрагивать височно-нижнечелюстной сустав и околоушную железу. В некоторых случаях процесс может затрагивать полость среднего уха, что чаще происходит у пациентов с сахарным диабетом или лейкемией.
-
Симптомы грибкового поражения среднего уха. Это заболевание обычно развивается на фоне хронического воспаления барабанной полости. Пациенты жалуются на ухудшение состояния, которое проявляется в ушных болях. Также наблюдается значительное снижение слуха, появление посторонних шумов и ощущение заложенности. Иногда могут возникать периодические головные боли.
-
Симптомы грибкового поражения барабанной перепонки. При грибковом мирингите процесс затрагивает барабанную перепонку. Слух значительно ухудшается, так как подвижность перепонки нарушается. Это происходит на фоне выделений из уха, выраженных болей и других симптомов воспаления.
-
Симптомы грибкового поражения послеоперационной полости. После мастоидектомии в образовавшейся полости, где ранее находились ячейки сосцевидного отростка, может начаться микотическое воспаление. Боли локализуются в области за ухом и в самом ухе, а объем выделений значительно увеличивается. При этом пациенты часто не обращаются к врачу, считая такие боли нормальными в послеоперационный период.
Врачи отмечают, что грибковые инфекции в ушах, хотя и встречаются реже, чем бактериальные, могут вызывать значительный дискомфорт и осложнения. Основными симптомами являются зуд, боль и выделения из уха. Специалисты подчеркивают важность своевременной диагностики, так как неправильное лечение может привести к хроническим проблемам. Врач-отоларинголог рекомендует не заниматься самолечением и обращаться за помощью при первых признаках инфекции. Для диагностики может потребоваться микроскопическое исследование выделений. Лечение обычно включает противогрибковые препараты, а также меры по устранению факторов, способствующих развитию грибка, таких как избыточная влажность. Врачи также советуют соблюдать гигиену ушей и избегать использования ватных палочек, которые могут усугубить проблему.

Причины появления грибка в ушах
Наиболее распространенной причиной поражения различных частей уха является сапрофитная микрофлора. Эти грибковые организмы обычно обитают на коже человека и не проявляют активности без предрасполагающих факторов.
Основные факторы, способствующие развитию грибка в ушах:
- Инородные предметы в ухе. Это могут быть любые посторонние объекты. Чаще всего такая причина становится толчком для возникновения микотического отита у детей, которые могут засовывать в уши камешки, кусочки бумаги, семена растений, пластилин, вату и другие предметы. У взрослых инородные тела попадают в ухо случайно, например, в результате травмы. У пожилых людей в ушах часто обнаруживаются детали слуховых аппаратов и батарейки от них. Грибок также может развиться из-за попадания воды в ухо.
- Травмы уха. Это включает повреждения наружного, среднего и внутреннего уха. Наиболее распространенной причиной микротравм является использование ватных палочек для чистки слухового прохода, что может привести к заболеваниям.
- Повышенная активность потовых желез.
- Инфицирование грибками рода Кандида. Это может произойти при генитальном или кожном кандидозе.
- Расчесывание ушной раковины. Это часто происходит при различных дерматитах (контактном, атопическом дерматите, экземе).
- Неправильная гигиена уха. Загрязнение или ощелачивание кожи наружного слухового прохода также способствуют развитию грибка.
- Узкий слуховой проход и экзостозы.
- Местный дисбактериоз. Он может привести к нарушению нормальной микрофлоры уха, особенно после различных видов отитов.
- Прием антибиотиков. Промывание уха растворами антибиотиков также может нарушить нормальную микрофлору.
- Снижение иммунной защиты организма. Нарушения обменных процессов и аллергические реакции всегда являются факторами риска для развития грибковой инфекции, в том числе и в ухе.
- Ношение слухового аппарата и частое использование наушников. Эти факторы также могут представлять угрозу для здоровья ушей.
Грибок в ушах — тема, которая вызывает много обсуждений среди людей, сталкивающихся с этой проблемой. Многие отмечают, что симптомы, такие как зуд и дискомфорт, могут значительно ухудшить качество жизни. Некоторые делятся опытом лечения, упоминая о необходимости обращения к врачу для назначения правильной терапии. Важно отметить, что самолечение может привести к осложнениям, поэтому консультация специалиста является ключевым шагом. Пользователи также обсуждают профилактические меры, такие как поддержание гигиены ушей и избегание влажной среды. В целом, общественное мнение подчеркивает важность осведомленности и своевременного обращения за медицинской помощью при первых признаках грибковой инфекции.
| Симптом | Возможная причина (тип грибка) | Лечение |
|---|---|---|
| Зуд в ухе | Aspergillus, Candida, Penicillium | Противогрибковые капли для ушей (например, клотримазол, нистатин), удаление ушной серы |
| Боль в ухе | Aspergillus (при глубоком поражении) | Противогрибковые капли для ушей, возможно системные противогрибковые препараты, в тяжелых случаях – хирургическое вмешательство |
| Выделения из уха (белые, желтые, коричневые) | Candida, Aspergillus, Malassezia | Противогрибковые капли для ушей, удаление ушной серы |
| Заложенность уха | Отек, вызванный воспалением из-за грибка | Противогрибковые капли для ушей, противоотечные препараты (по назначению врача) |
| Потеря слуха | Накопление выделений, отек | Удаление выделений, противогрибковые капли для ушей |
| Покраснение и отечность наружного слухового прохода | Аллергическая реакция на грибок, воспаление | Противогрибковые капли для ушей, противовоспалительные препараты (по назначению врача) |
Лечение грибка в ушах
Для эффективного лечения грибка в ушах необходимо использовать антимикотические препараты. В процессе терапии проводятся промывания среднего и наружного слухового прохода, а также послеоперационной полости с различными антимикотическими растворами. В первую очередь выполняется туалет уха, который включает очищение от отмершего эпидермиса, выделений, серы и мицелия грибка.
Чтобы выбрать подходящее средство, важно определить вид грибка, вызывающего воспаление:
- Туалет уха можно проводить с использованием различных лекарственных и антисептических растворов. Скопление экссудата или казеозных масс является серьезным источником грибковой инфекции, поэтому их удаление должно быть тщательным. Для этого можно применять перекись водорода или 3% раствор борной кислоты. Также возможно смазывание кожного покрова слухового прохода 5-10% раствором нитрата серебра.
- Для местного лечения предпочтительными являются хлорнитрофенол и 1% раствор нафтифина. Эти препараты используются в виде аппликаций на коже наружного слухового прохода в течение 10-14 дней. Также можно закладывать в ухо мази, такие как Нистатин и Леворин. В некоторых случаях растворы закапываются непосредственно в ухо (при условии, что барабанная перепонка не повреждена) или наносятся на вату и вставляются в наружный слуховой проход.
- Если при микологическом посеве выявлены грибы рода Candida, назначаются аппликации с комбинацией препаратов: 1% раствор клотримазола и 1% раствор нафтифина на протяжении 10-14 дней с продолжением терапии еще на 14 дней.
- В случае недостаточности местного лечения или рецидивов заболевания местная терапия должна быть дополнена системными препаратами. Рекомендуется назначение флуконазола.
Хирургическое вмешательство может потребоваться при осложнениях, таких как мастоидит и хронический холестеатомный процесс с вторичным отомикозом. Операция также показана, если консервативные методы не позволяют избавиться от грибка в послеоперационной полости.
Лечение грибка в ушах представляет собой сложную задачу, однако прогноз обычно благоприятный, особенно если пациент своевременно обращается за медицинской помощью. Если грибок локализуется в среднем ухе и его причиной становится спаечный процесс, снижение слуха может оказаться необратимым. При тяжелом течении заболевания грибок может распространиться на внутренние органы и вызвать грибковый сепсис. Поэтому терапия должна быть своевременной и квалифицированной.

Вопрос-ответ
Как понять, что у тебя ушной грибок?
Ушной грибок может проявляться такими симптомами, как зуд, жжение в ушах, выделения из уха (часто с неприятным запахом), ощущение заложенности или боли. Если вы заметили эти признаки, особенно в сочетании с ухудшением слуха, рекомендуется обратиться к врачу для диагностики и лечения.

Как избавиться от грибка в ухе?
Для лечения отомикоза используются местные средства — противогрибковые, антисептические, подкисляющие растворы, глюкокортикоиды. Местные противогрибковые препараты — препараты выбора для лечения отомикоза. Чаще используется 1% раствор клотримазола, применяемый дважды в день в течение 10–14 дней.
Можно ли капать перекись при отомикозе?
Режим. Больному уху необходимо обеспечить покой. Перед лечением его очищают от выделений и мертвого эпителия с помощью перекиси водорода.
Советы
СОВЕТ №1
Регулярно очищайте уши от серы, но делайте это осторожно. Используйте для этого специальные капли или ватные палочки, но не углубляйтесь слишком глубоко, чтобы не повредить слуховой проход.
СОВЕТ №2
Избегайте попадания влаги в уши, особенно после купания или душа. Используйте беруши или специальные шапочки для плавания, чтобы защитить уши от воды.
СОВЕТ №3
Если вы заметили зуд, дискомфорт или выделения из уха, не откладывайте визит к врачу. Раннее обращение за медицинской помощью поможет предотвратить развитие грибковой инфекции.
СОВЕТ №4
Поддерживайте иммунную систему, употребляя продукты, богатые витаминами и минералами. Здоровый образ жизни и сбалансированное питание помогут вашему организму бороться с инфекциями, включая грибковые.